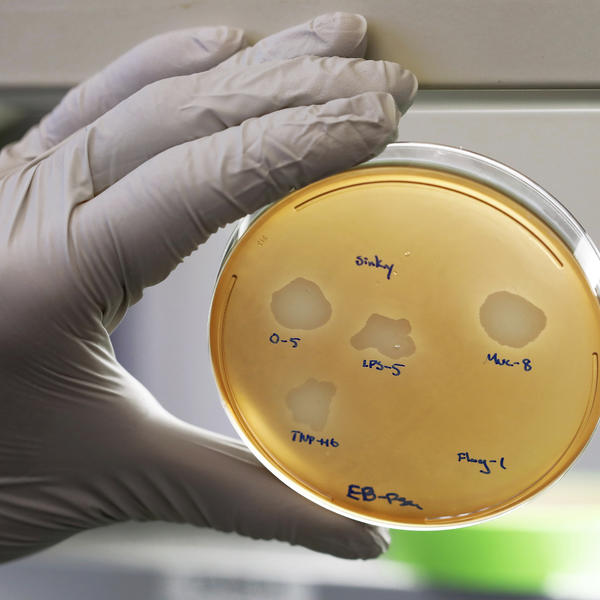

čuda su moguća
ONA JE DOKAZ DA SU ČUDA MOGUĆA! Dobila je RAK KOSTIJU i rekli su joj da NEĆE IMATI DECU - onda se sve preokrenulo!
Rečeno joj je da ima nula odsto šansi da zatrudni, kako prirodnim putem tako i vantelesnom oplodnjom
Kara Njuton (36) iz Hemšira 2009. godine čula je najužasniju vest - da boluje od retkog tipa raka kostiju. Kada je primetila da joj se nešto čudno dešava sa levom nogom, verovala je da je povredila mišić. Međutim, kako se situacija nikako nije poboljšavala, na kraju je otišla do lekara gde je ustanovljeno da zapravo ima veoma agresivni tip raka kostiju, Juingov sarkom.
Tretman je usledio odmah, kako bi se sprečilo dalje širenje po telu, a kako bi sprečili amputaciju, lekari su izvadili zaraženu kost iz njene noge i zamenili je protezom. Usledile su naporne hemoterapije a Kara je oduvek želela da zasnuje svoju porodicu, pa je pitala lekare da pre hemoterapije zamrzne svoje jajne ćelije.
Njena molba je odbijena, jer joj je rečeno da ima nula odsto šansi da zatrudni, kako prirodnim putem tako i vantelesnom oplodnjom.
- Sa 26 godina pretila mi je menopauza, a jajne ćelije su mi uništene hemoterapijom. Imala sam samo jednu menstruaciju od 2009. godine. Bila sam uverena da suprug Kris i ja nikad nećemo imati dete - kaže Kara.
Kara je, međutim, odbila da se preda i Kris i ona nadali su se čudu. Tako, tri godine po završetku hemoterapije, ona je nekim čudom zatrudnela i rodila malog Sebastijana koji danas ima pet godina. Nekih godinu i po dana kasnije, usledio je šok jer je Kara opet primetila izrasline na nozi.
- Bila sam očajna i uverena da se rak vratio i da će Sebastijan ostati siroče. Prosto nisam mogla da zamislim da prolazim kroz hemoterapiju drugi put - kaže Kara. Na svu sreću, ispostavilo se da masa koja se pojavila nije bila kancerogena.
A onda je usledilo novo čudo - zove se Džesika i danas ima dve godine. Kara ima problema jer joj telo uporno odbija protezu, ali lekari daju sve od sebe da izbegnu amputaciju.
- Možda će mi i amputirati nogu, ali trudim se da o tome ne razmišljam. Svakog dana sam srećna i zahvalna što sam od nula posto šansi da zatrudnim sada srećna majka dvoje dece - kaže Kara.
Bonus video:
(Espreso.co.rs)
Uz Espreso aplikaciju nijedna druga vam neće trebati. Instalirajte i proverite zašto!